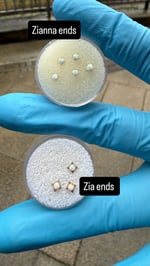

Anatometal Gold ends.
£45.00 - £180.00
ASTM F-136 certified implant grade titanium, Niobium and 18ct Solid Gold. Each item is hand polished to a mirror finish for an extremely smooth surface and of course, carries a lifetime guarantee against defects!
Sold as singles, for pairs please order two.
Sold without labrets, please add to the order if these are required.
Also carries manufacturers guarantee. Does not cover loss.